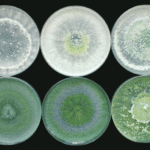

Description
A powerful bio control agent and antibiotic producer
- Powerful Biocontrol Agent – Effectively suppresses fungal diseases like root rot, wilt, damping-off, and collar rot.
- Parasitic Action – Attacks and destroys harmful fungi by coiling around them and secreting cell-wall degrading enzymes.
- Antibiotic Producer – Produces antifungal metabolites that stop pathogen growth.
- Rhizosphere Protector – Rapidly colonizes the root zone, forming a protective barrier.
- Plant Growth Promoter – Enhances root development, nutrient absorption, and plant vigor.
- Stress Tolerance – Improves plant resilience against drought, salinity, and soil-borne stress factors.
- Eco-Friendly & Safe – 100% natural, residue-free, and certified for organic farming.
Cereals, Pulses, Vegetables, Fruits, Plantation crops, Spices, and Ornamentals
| Seed Treatment | 10 ml per kg of seeds |
| Seedling Treatment | 100 ml in 10 litters of water |
| Soil Application | 2L/acre in 100 kg of well decomposed organic manure |
| Drip Irrigation | 2L/acrealong with irrigation water |
| Sett Treatment | 100 ml in 10 liters of water |
- Mycoparasitism: Trichoderma coils around pathogenic fungi and penetrates their cells, destroying them.
- Competition: Outcompetes harmful microbes for nutrients and space in the rhizosphere.
- Antibiosis: Produces natural antibiotics and metabolites that kill or suppress pathogens.
- Enzyme Secretion: Releases chitinase, glucanase, and cellulase that degrade pathogen cell walls.

There are no reviews yet.